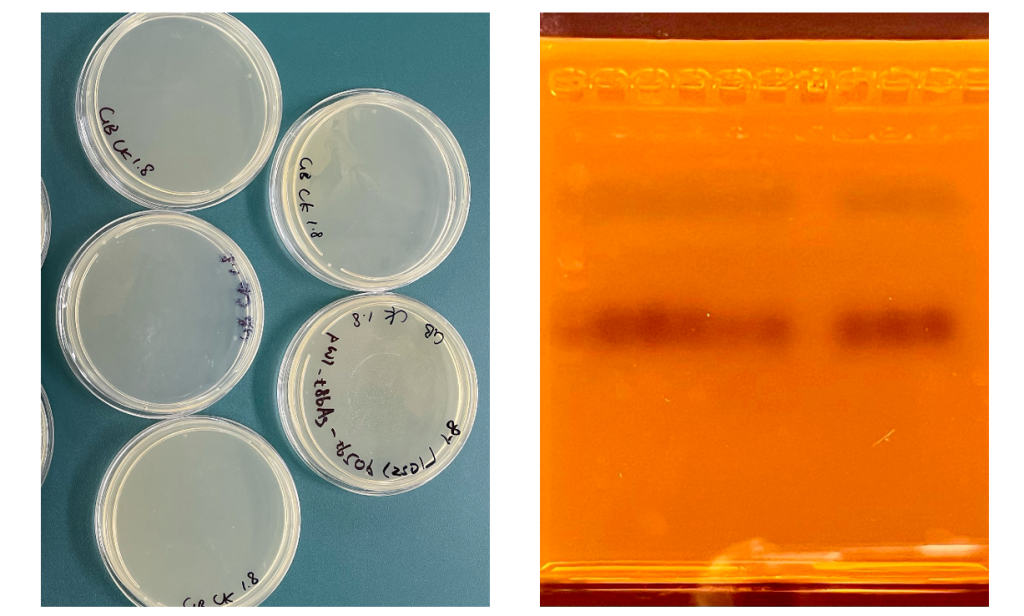

SCIE has once again welcomed its annual Science Week.
As the school’s iGEM team (GreatBay-SCIE 2025), we have always believed that science should not just stay in textbooks; it should be truly “seen, touched, and practiced.” Bringing synthetic biology to more students is our simple wish.
What is Synthetic Biology?
Synthetic biology is a cutting-edge field that applies genetic engineering to construct, redesign, and even create entirely new biological systems.
If genes are like lines of code, then synthetic biology is the process of helping humans “program” life, letting organisms to achieve specific goals.
This Year’s Theme: Geraniol Synthesis
This time in the lab, we became “perfumers.” Using biological methods, we synthesized a citrus-scented compound—geraniol.
This experiment is also one of the key branches of the GreatBay-SCIE 2025 iGEM project.
We attempted to build a “mini factory” inside microorganisms. By designing a catalytic pathway, we enabled microbes to convert simple carbon sources into geraniol through a series of enzyme-catalyzed reactions.

This year, we conducted three sessions:
Two 2-hour immersive experimental workshops.
One “Scent Verification” result drop-in session.
But unlike previous years, we made a bolder decision: to let participants complete as many experimental steps as possible themselves, experiencing a full experimental workflow.
Because we believe that theory alone is never enough. True understanding often happens the moment your hands touch a test tube, a micropipette, or a culture plate.
So we guided students through four core molecular biology techniques:
Transformation
Colony PCR + Gel Electrophoresis
Inoculation
Induction
This was a massive and complex workflow—challenging for everyone involved.
But it’s precisely this challenge that made the experience unforgettable.


Preparation | Behind the Scenes
Preparation began more than a month before Science Week. Before the Christmas break, we held multiple meetings to finalize the plan and submit proposals to the school. After Christmas, we entered a four-week pre-experiment phase.
To put this in perspective: running this entire experimental pipeline normally takes over a month and a half.
We compressed it into just four hours during Science Week.
Bacteria grow slowly. Variables are everywhere. One wrong step can wipe out an entire week’s work.
We knew the risks, but we chose to face the challenge head-on.
Reality Was Even More Twisted
The pre-experiments did not go smoothly. We faced:
Transformation failures.
Strange bands.
“Terrifyingly clean” agar plates.
Gel images with no results.
Problems came one after another.
Sometimes teachers could help us analyze the cause, but more often, we had to rely on ourselves.
Drawing on the experience we had accumulated from working closely with these strains for over half a year, we kept replacing reagents, adjusting parameters, optimizing protocols, and starting over again and again.
Failure was not the exception — it was simply the most authentic part of doing experiments.
Finally—after three weeks—every pre-experiment worked.
But the real challenge wasn’t just making the experiments work.
It was ensuring that within a two-hour session, every group could complete the workflow stably and controllably.
The workshop schedule was extremely tight. Any delay at any step could cause the entire session to run overtime.
So we rehearsed the full process repeatedly—timing every step, breaking procedures down, optimizing transitions.
We also prepared contingency plans, such as using alcohol lamps to create sterile zones if clean benches were insufficient.
No matter what happened, we wanted the experience to go smoothly.
Simultaneously, we prepared:
Safety Manuals
Experimental Protocols
Student Workbooks
Teaching Slides


Rehearse, revise, review, rehearse again… We’ve lost count of how many rounds it took.
There were moments of emotional breakdown. Moments when giving up felt tempting.
But in the end—When Science Week arrived, we were ready.
On-Site | Real “Hands-on Science”
On the day of the event, staff were divided into 7 groups, each with a leader responsible for guidance and detailed explanations.
Opening Introduction by Lucas:
Basic concepts of Synthetic Biology.
The overall logic design of geraniol synthesis.
During the waiting periods between experimental steps, each group leader would make full use of the time to:
explain the scientific principles behind every procedure,
play videos or live demonstrations to walk students through the complete workflow, and
help them build a clear understanding of the overall experimental logic.
In this way, the experience went beyond simply doing experiments — it became about truly understanding the science.
After every session, we collected feedback from participants and continuously refined the workshop. Based on their responses, we:
adjusted the pace and depth of our explanations, and
improved the organization of the experimental procedures.
Students also reflected on their learning in the questionnaires, thoughtfully recording what they had gained from each session.
Seeing the students truly understand and practice—at that moment, all the effort felt worth it.
The “Dark” Moment of Success
At the end of the second workshop, we reached an unforgettable moment.
To clearly observe the gel results under blue light at 6:30 PM, we turned off all the lights. The lab fell into darkness, save for the faint glow of the equipment.
Everyone crowded around the screen, holding their breath as the camera revealed the results. One by one, clear bands emerged.
Every single one was correct.
(It was the most perfect gel since we started the pre-experiments.)
Cheers and applause erupted, echoing through the lab.
That sense of achievement was irreplaceable.


Gratitude
Behind our busy figures at the lab benches stands a group of people who silently support us.
Special thanks to the Biology Department teachers and lab technicians. You helped us troubleshoot when transformations failed and analyzed directions when experiments stalled. You strictly monitored safety and standards at every critical node.
You may not have stood at the front, but you were the ones ensuring our ideas became reality.
Thank you – for making this Science Week possible.
- Article / Lucas & Tatiana
- Pictures / Ms Claire, Ms Sonia, Ms Ellie, Lucas, Tatiana, Andy, Lucy
- Experimenters / Lucas Tu, Tatiana Yao, Murphy Sun, Tom Lu, Brandon Wu, Nicole Yu, Isabella Wang, Jeremy Han, Derek Li, Lucy Cai, and Andy Jin


















